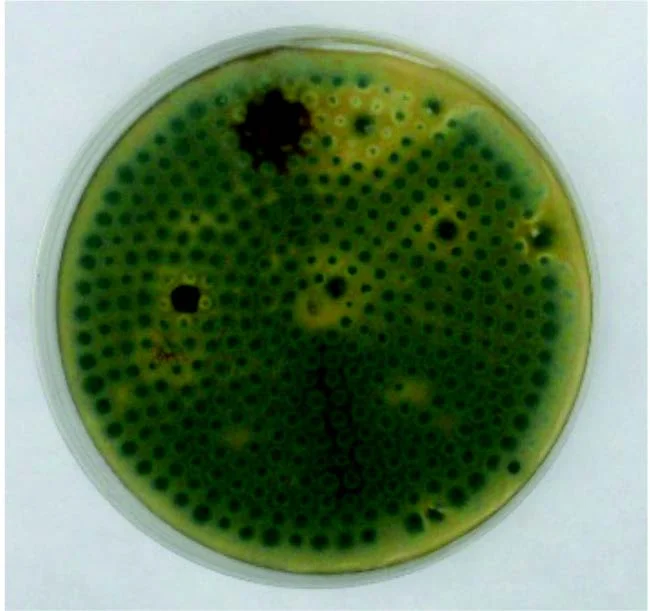

Containers
Research Results using Bluezone® Fresh Preservation Technology
Refrigerated Storage FFV Research Trials
Introduction
FF&V demonstration tests were conducted in side-by-side, 20’ reefers to measure the effectiveness along the global refrigerated supply chain in sea containers. Test were conducted to measure optimized ventilation, reduced ethylene and longer distance shipping of sensitive produce (FF&V).
The Bluezone system was integrated into reefer above the evaporator allowing ventilation reduction (for energy reduction), temperature stability, reduction in defrost cycling, and moisture control. It worked in the background, continuously cleaning the air of ethylene and mould. There was no downside or incompatibilities as it was retrofit into existing inventory.
The system had no impact on available container volume and required only very low power consumption (the system can be applied to a container of any size : 20’, 40’, 40’ high cube)
Bluezone® is shown here fully integrated into the Starcool Container, between the evaporator fans.
Patented Bluezone® Technology Uses UV-enhanced Ozone.
Inside the Bluezone® germicidal UV light and ozone clean the air; ozone is removed with a catalyst; Nothing gets back into the cooler but freshness.
Ethylene pull-down data for integrated design in container with 38m3 open volume, for 0C and 13C.
Additional testing shows that pull down rate is not affected by CO2 concentration or humidity.
We have measured steady state ethylene concentrations at <0.1ppm using manual measurement of the low ethylene peaks from the chromatogram.
Ethylene levels corresponding to a kiwi or green banana load (2.2 mg/hr ethylene generation rates) are confirmed to be at or below 0.1 ppm.
Bluezone® enhances CA, particularly in the early stages before carbon dioxide and oxygen reach their steady state levels.
Bluezone On
Time = 0 hours
Bluezone On
Time = 1 hour
Conclusion
Shelf life extension of 7 – 8 days on average. Specific fruits and vegetables have shelf life extensions up to 15 days longer than without Bluezone. Rapid respiration rate was reducedin whole load from a few ripe pallets. There was no impact on refrigeration performance or capacity due to installation design.
Bluezone provided significant benefits to the shipping of most fruits, vegetables, and flowers. It extended shelf life, improved product quality and allowed optimal ventilation for energy, temperature control and moisture retention.
It reduced the risk of a rapid load ripening of bananas, kiwi and tropical fruits (cherimoya, passion fruit, papaya, mango). Also it preserved mixed loads and allowed for flexibility in logistics.